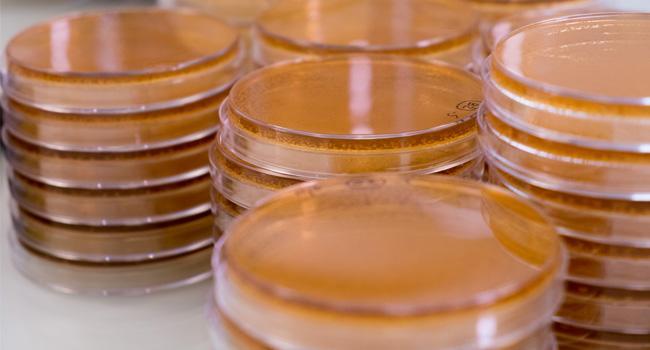
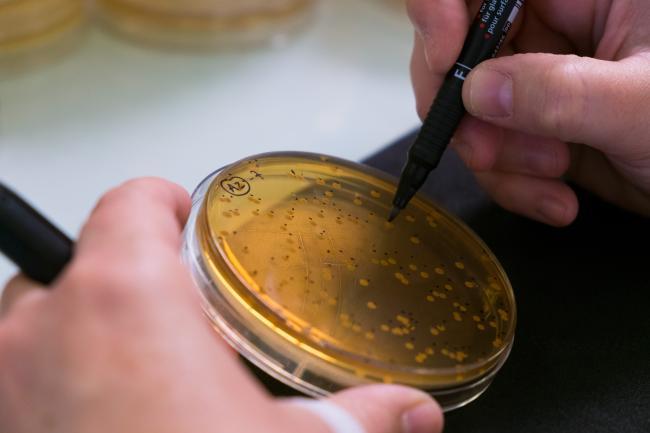

Origine et innocuité des souches
Certification
Les microorganismes probiotiques destinés à être consommés par l’homme doivent avoir une innocuité parfaite et par conséquent ne présenter aucun risque de toxicité.
Sur ce principe, ont été dressé des listes de ces microorganismes jugées historiquement comme sûrs pour l’homme : on parle de microorganisme à statut QPS (Qualified Presumption of Safety) en Europe, ou GRAS (Generally Recognized As Safe) aux Etats-Unis.
Ces listes comportent un certain nombre de genres, d’espèces voire de souches de bactéries probiotiques.
Toutes les souches de bactéries utilisées par PiLeJe pour l’élaboration de ses solutions de santé sont issues de groupes de bactéries ayant le statut QPS et/ou GRAS.

« Non antibiorésistance »
Par sa présence dans l’intestin, le probiotique ne doit pas par lui-même ou via son action sur les autres bactéries intestinales, provoquer une éventuelle résistance bactériologique à un traitement antibiotique : c’est le critère de « non antibiorésistance ».
Inscription à la Collection Nationale de Culture de Microorganismes
Chaque souche de probiotique sélectionnée par PiLeJe est étudiée de manière à en définir ses propriétés intrinsèques (morphologie, résistance à l’humidité, à la chaleur, conditions de croissance, etc.) et génotypiques (séquençage de l’ADN bactérien).
La souche, ainsi analysée et dès lors parfaitement connue, est enregistrée auprès de la Collection Nationale de Culture de Microorganismes (CNCM).
Cette inscription garantit une parfaite traçabilité des souches entrant dans la composition d’un complément alimentaire.
Pourquoi des critères de sélection aussi stricts ?
Au sein des différents genres et espèces de bactéries potentiellement utilisables comme probiotiques, on retrouve une grande quantité de souches bactériennes. Chacune a ses propriétés propres que ce soit au niveau « cible santé » potentielle ou au niveau condition de culture, viabilité, stabilité, adhésion à la muqueuse intestinale pour y exercer son action, etc.
Toutes les souches bactériennes ne sont donc pas pertinentes pour la réalisation d’un complément alimentaire.
Ce n’est qu’après avoir passé de nombreux tests techniques que PiLeJe sélectionne les souches les plus pertinentes pour entrer dans une formulation donnée.
Gastrorésistance
Pour exercer leurs propriétés bénéfiques sur l’hôte, les probiotiques doivent être capables de résister aux conditions rencontrées tout au long du tube digestif et d’atteindre l’intestin grêle et/ou le côlon sous forme viable.
Pour vérifier la résistance des souches aux différents obstacles que les probiotiques sont amenés à franchir au cours de leur transit, on a recourt à des modèles in vitro qui reproduisent les conditions (pH, sécrétion d’enzymes digestives, péristaltisme) retrouvées dans les différents compartiments digestifs : estomac, intestin, côlon.
Ces études spécifiques permettent par exemple de sélectionner des souches résistantes au compartiment gastrique (résistance au pH acide, à des enzymes telles que la pepsine) ou intestinal (résistance aux sels biliaires, à des enzymes pancréatiques).

Adhésion à la muqueuse intestinale
Les probiotiques ne sont pas des « actifs » comme les autres.
Ils ne sont pas absorbés par l’organisme. Ils agissent localement et, pour ce faire, doivent adhérer à la muqueuse intestinale et en quelque sorte « se mêler » au microbiote de l’hôte, c'est-à-dire à la flore intestinale déjà présente (appelée aussi parfois flore commensale).
Cette capacité d’adhésion aux cellules intestinales les rend capable d’interagir à leur tour, comme le microbiote, avec le système immunitaire intestinal et le système nerveux présent à ce niveau.
Plus la capacité d’adhésion de la souche probiotique est importante, plus son temps de présence au niveau intestinal est augmenté et plus son action potentielle à interagir avec l’organisme augmente.
Des tests in vitro permettent de sélectionner les souches probiotiques ayant les capacités d’adhésion à la muqueuse intestinale les plus performantes.
Viabilité et stabilité dans le temps
Les souches bactériennes étant fragiles, il est indispensable de maîtriser leurs conditions de croissance et de connaitre leurs conditions de viabilité dans différents milieux.
De multiples expériences sont réalisées comme par exemple la mise des souches bactériennes en « étuves de vieillissement » pour étudier leurs critères de viabilité dans le temps.
Les données collectées conditionneront le choix des excipients, des potentiels ingrédients complémentaires, et des matériaux galéniques. Tous devront être « compatibles » avec la souche probiotique, c'est-à-dire ne pas nuire à son action ni à sa stabilité dans le temps.
